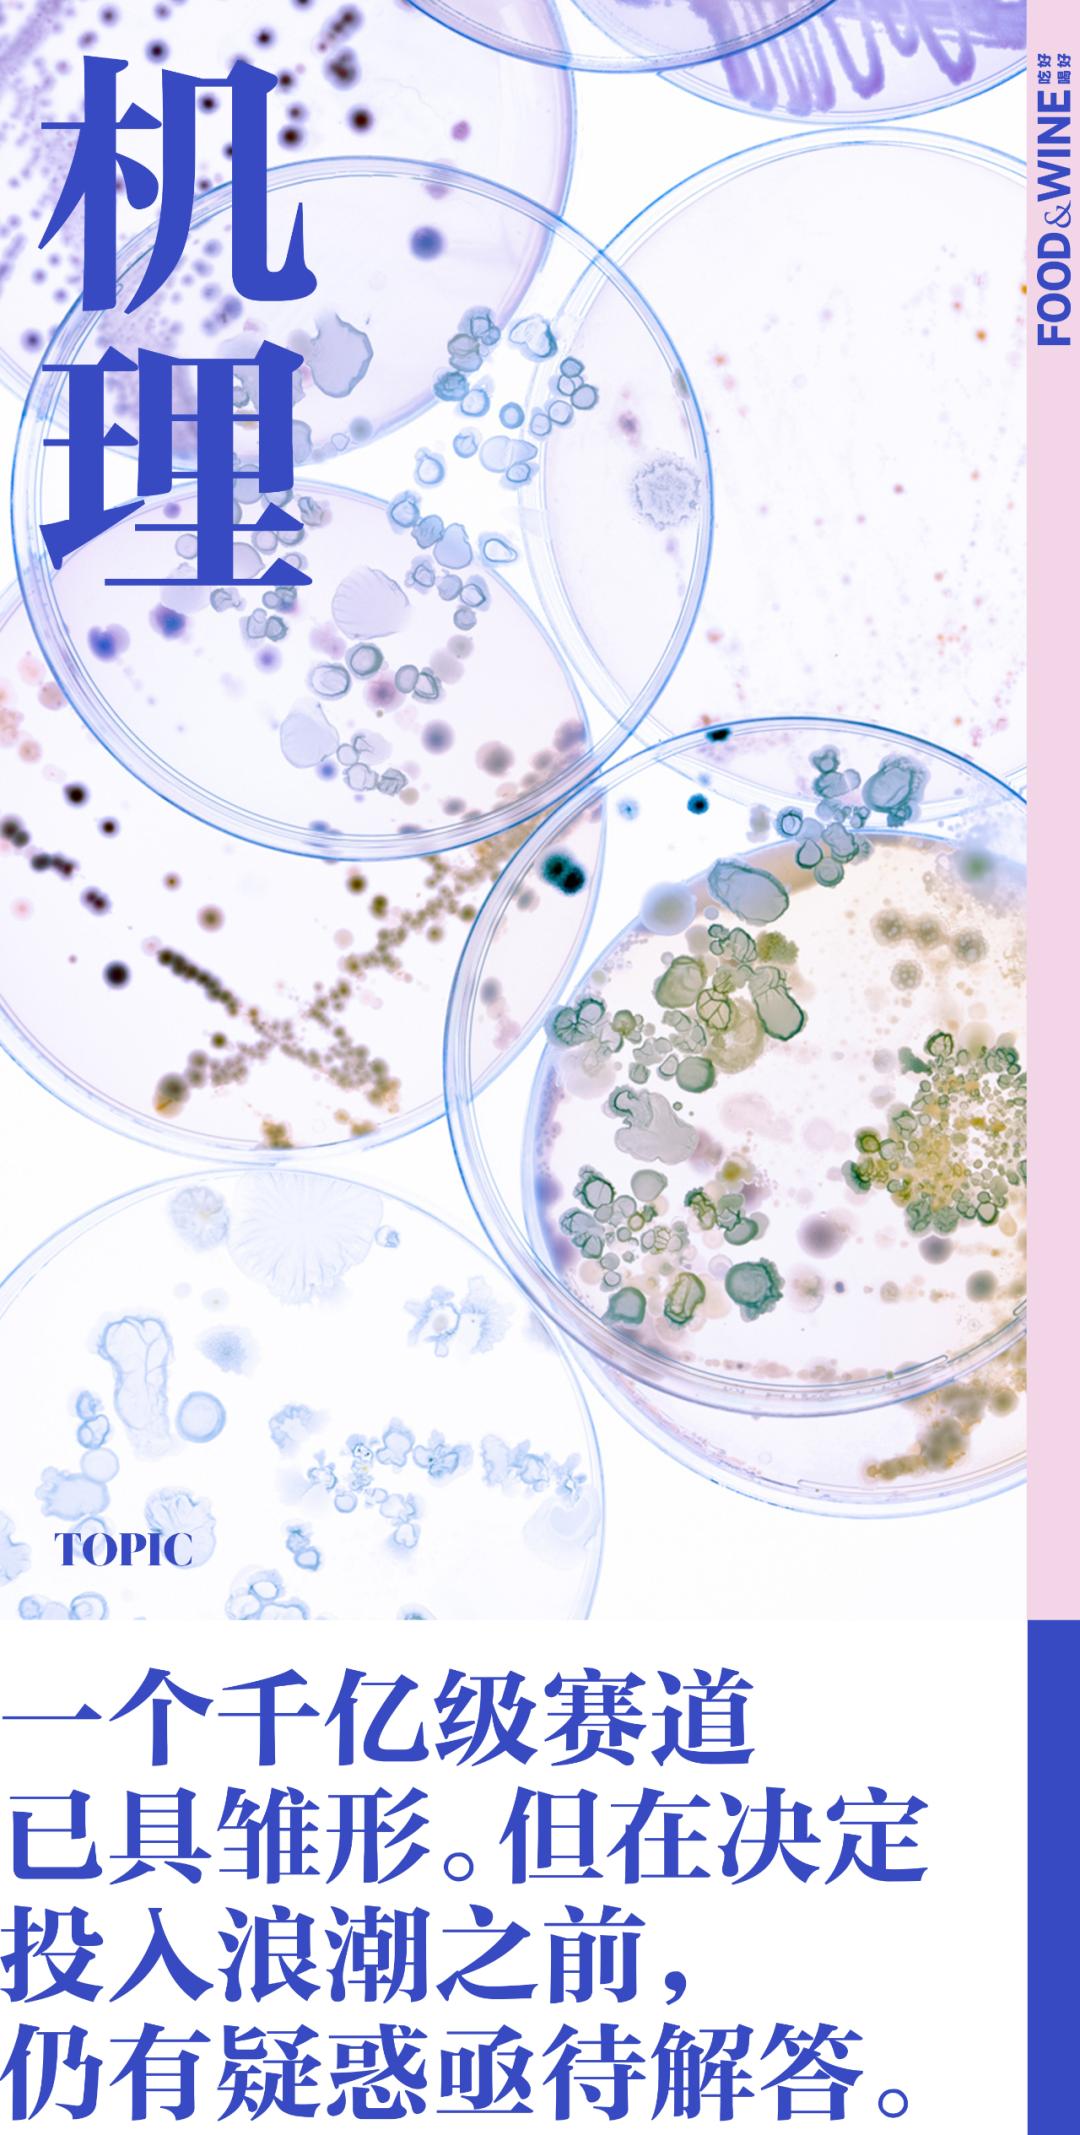
理性对待益生菌,如何理性看待益生菌

为了相对「体面」地迎接露肉的季节,你做过多少努力?
伴随地球以每秒 30 公里的速度绕太阳自西向东转动一周,消费市场上的体重管理类产品也经历着一轮又一轮的「公转」。燃脂贴、酵素果冻、代餐奶昔、螺旋藻、白芸豆……不断涌现的新产品和新概念,在社交网络精心构筑的「完美标准」里肆无忌惮地吹奏响亮的号角,前赴后继地充当再下一个减肥周期里的「加速神器」。
2023 年,这股风已经被赋予了具体的样貌 —— 一种带甜味的白色粉末。「400 亿 CFU 活菌,『益』起大吃大喝,不惧腹担」。面对这样的宣传口号,大部分消费者对前半句话的具体含义并不明晰,继而产生「400 亿是什么概念?」「CFU 是什么意思?」诸如此类的疑惑。但结合后半句语意明确的暗示,二者便形成了恰到好处的共振,大大提高了整句话的说服力。
作为时下火热的大健康产业下又一个细分,益生菌市场正被诸多新消费品牌的入局彻底搅活,一个千亿级赛道已具雏形。不过在决定投入这股浪潮之前,亟待解答的问题仍有许多。为此,我们向 IFF Health 亚太区菌种和益生菌研发中心负责人、微生物科学家毛跃建博士发出邀请,聊聊益生菌的前世今生、作用机理,和挑选原则。
以下是毛跃建博士的讲述,内容存在编辑和删减。

以 WonderLab 为代表的的新消费品牌入局,带动了益生菌产业的快速发展。© WonderLab
近年来,全球益生菌市场呈稳步发展,伴随行业下游终端消费场景的扩张,益生菌的应用领域也向多元化延伸,例如:乳制品、奶粉、膳食补充剂、美容日化等。总体而言,中国消费者对益生菌的认可度较高,尤其是在改善肠道及消化健康方面的益处上面。
行业的快速发展吸引了越来越多企业和资本进入。一方面,它们推动了整个产业的快速发展;另一方面,也导致了市售产品鱼龙混杂,质量参差不齐的情况。由于益生菌产业在我国发展时间较短,且发展极为迅速,因此法规和监管手段都还存在一定滞后性。部分网上销售的产品存在夸大宣传的嫌疑,甚至有些标注为益生菌的产品根本不含真正的益生菌成分。消费者因此对益生菌产生怀疑,继而将其划入「智商税」的行列也是很正常的现象。

益生菌 (Probiotics)一词,源于拉丁语「For Life」,即「对生命有益」。2001 年世界卫生组织(WHO)对益生菌的定义是这样的:一类活的微生物,当摄入合适数量时有益于宿主(人体)健康。
拆解一下,成为益生菌需要满足 3 个条件:首先,益生菌必须是活的微生物,因此保证产品的稳定性和活性非常重要。其次,需要摄入合适的数量。以目前常见的益生菌为参照,一般每次需要摄入数十到上百亿 CFU (衡量益生菌数量的单位)活菌。需要特别说明,不同菌株之间存在差异性,想要了解每个菌株的有效摄入量,可以参考对应研究中所使用的有效剂量。最后,也是最重要的一点,作为益生菌,需要有严谨的科学实验和证据来证明它确实能给人带来健康益处。

发酵食品是益生菌的常见来源之一。© iStock
人类食用微生物的历史几乎与人类存在的历史一样长。早在石器时代,发酵食物就已存在于人类的生活中。在相对漫长的岁月里,我们虽然还不知道微生物的存在,却已经频繁地将各种发酵食物,如啤酒、面包、葡萄酒、酸乳酒、酸马奶酒和奶酪等,应用于营养补充,甚至疾病治疗。
17 世纪,荷兰人 Antonie van Leeuwenhoek 发明了显微镜,人类第一次看到了微生物。时间来到大约 200 年后的 1857 年,法国科学家 Louis Pasteur 第一次证实:食物的发酵是微生物引起的。他还发现了乳酸菌。1899 年,法国巴斯德研究所的 Henry Tissier 率先从健康的婴儿粪便中分离了第一株双歧杆菌。Henry 认为双歧杆菌是通过母乳喂养的婴儿肠道菌群中的主要微生物,并指出如果双歧杆菌可以使致病有害细菌的失衡正常化,就可以治愈急性胃肠炎。可以说,他是第一个提出「友好细菌可用于治疗肠道疾病」这一想法的科学家。

Élie Metchnikoff 在 20 世纪初首次提出了在肠道中种植有益细菌的可能性。© Zbiotics.com
不过在绝大部分的科学论文中,乌克兰科学家 Élie Metchnikoff 才被认为是「益生菌之父」。他在 1908 发表的著作《寿命延长:乐观的研究》中提出,一些肠道微生物的吞噬作用会产生有毒物质,导致衰老;如果可以阻止这些有害微生物的作用,则可以延长寿命。当时保加利亚山区的村民习惯食用大量的发酵乳制品,事实上他们确实比一般人长寿。因此 Élie Metchnikoff 推断乳制品中的乳酸菌可以通过产生乳酸来降低肠道中的 pH 值,并抑制有害微生物的生长,从而延长寿命。这也就是我们现在所熟知的「酸奶长寿理论」或「乳酸菌长寿理论」。

随着高通量测序技术的快速发展,近 20 年来的研究表明,肠道菌群对人类的健康有着非常重要的作用。它影响的不仅仅是肠道内部环境,还通过影响肠上皮细胞、肠道内神经细胞,以及免疫细胞等影响着我们的健康。相应的,肠道菌群失衡不仅仅会引起肠易激综合征 (IBS)、炎症性肠病(IBD)等肠道疾病,还可能会引起内分泌、免疫、神经、皮肤、心血管、呼吸道及尿道等方面的疾病。
理论上来说,因肠道菌群失调引起的各种疾病,都可以通过调节肠道菌群来进行预防、缓解或治疗。目前常见的肠道菌群干预手段主要由有 5 大类:益生菌、粪菌移植、饮食控制、基因改造过的共生菌以及微生物来源的蛋白或代谢产物。其中,益生菌是天然来源的活性微生物,安全性高,可以直接补充肠道内的有益微生物。

将益生菌产品与体重管理绑定,是益生菌品牌常用的营销方式之一。© Shonutrition.com
除了可以预防和改善肠道相关的一些疾病,益生菌还可能作为代谢性疾病的辅助性治疗方式,比如肥胖、代谢综合征、非酒精性脂肪肝及 II 型糖尿病等 (这里需要明确的是,不同益生菌菌株的健康作用并不相同)。
从作用机制上来说,当足够数量的益生菌进入肠道,就会启动三种方式来调整肠道菌群:第一,通过与有害菌竞争肠道表面定殖的位置,从而减少有害菌的生存空间。第二,通过与有害菌竞争营养物质,从而降低有害菌生长繁殖的速度。第三,益生菌在生长过程中会分泌有机酸、细菌素等抑菌物质,可以起到抑制致病菌、改善肠道环境的作用。

Yakult 养乐多是一种含有活性干酪乳杆菌代田株的益生菌饮料,主打改善肠道功能。© 养乐多活性乳酸菌
在此基础之上,益生菌合成的代谢产物也会影响我们的身体。肠道中数万亿的微生物就像一个大型的代谢工厂,通过发酵,将食物成分转换成各种小分子物质。其中很多物质会在肠道中被人体吸收,进入血液循环,进而影响身体其他部分。益生菌可以提高一些对人体有益的代谢产物的量,比如短链脂肪酸、吲哚、维生素及氨基酸衍生物等。以短链脂肪酸为例,它可以提升肠屏障功能、抑制炎症反应、降低代谢性疾病的风险。另一方面,益生菌可以降低一些对人体健康不利的物质的产生,比如氧化三甲胺 (TMAO),从而降低心血管疾病的发病率。
至于益生菌对免疫系统的调节作用也很好理解。人体 70% 的免疫细胞驻扎在肠道中,可以说肠道是我们最大的免疫器官。益生菌可以降低肠道中内毒素 (LPS)的量,降低其进入血液循环后而引发的全身性炎症反应;还可以影响肠细胞分泌到肠腔内的分泌型免疫球蛋白(sIgA),帮助清除肠道中的有害菌和有害物质。

虽然接触益生菌的消费者越来越多,但是很多人对益生菌依然存在一些认知上的误区,甚至有时候会出现两种截然相反的观点:「益生菌万能论」和「益生菌无用论」。在我看来二者都太过于极端。
一些消费者误以为益生菌是一个东西,都一样。事实上,益生菌是一个总称,涵盖了很多不同种类、作用各异的微生物。也有消费者认为同一种益生菌作用就相同,但实际上益生菌具有「菌株特异性」,简单举例,嗜酸乳杆菌 NCFM 和嗜酸乳杆菌 La-14 都叫嗜酸乳杆菌,其功能却有很大差异。

益生菌具有「菌株特异性」,在同一种名下还需要区分菌株名。© Getty Images
当我们将益生菌作为一个类别,列举它具有的各种功能时,其实是汇总了很多不同益生菌菌株的作用。因此,对于不了解益生菌菌株功能差异的人来说,会有一种益生菌包治百病的错觉。反之,在不了解益生菌菌株特点的情况下随意选取益生菌,则很有可能无法满足所期望的健康诉求,从而认为益生菌一无是处。
此外,由于我们每个人的遗传背景、肠道菌群是存在差异的,因此不同人对于同一株益生菌的响应也存在个体差异。也就是说,即使是对大部分人有效的益生菌,也可能会对少数人成效甚微。

目前市售的益生菌种类繁多,价格差异巨大,质量参差不齐。以下一些挑选原则,或许可以帮助你购买到最合适自己的产品:
① 看菌株: 对于只标注了种名而没有标注菌株名的产品,一般不建议购买。因为这类产品很难去考证它的研究功效。
② 看作用: 可以通过菌株名去查询相关文献,来了解产品中所含菌株的哪些健康功效是被验证过的。那些经过专业审稿人审核后发表的科学文献,可以提供相对可信的功能证据。

以 WonderLab 为例,包装上标注的「400 亿」是指生产时益生菌添加量为 400 亿 CFU / 瓶。© WonderLab
③ 看活菌数: 首先需要挑选活性益生菌,由于相关法规的滞后性,一些并不符合益生菌定义的死菌产品仍在市面上流通。其次,不同品牌的产品,成分标注方法可能不同,大家在做比较的时候需要留意,是每克的含量、每袋的含量,还是每盒的含量。最后,需要注意看产品宣称的量到底是生产时添加的量、出厂时的量,还是货架期(最佳食用期限)内的量。这三者有明显区别,特别是对于那些稳定性不佳的益生菌来说,添加相同数量的情况下,到消费者手里时的活菌数也可以千差万别。
④ 看稳定性: 益生菌从发酵生产出来到被人体摄入到达肠道,主要面临生产、存储、消化这三个阶段的稳定性挑战。对于标注了出厂活菌数的产品,消费者就不需要考虑它在生产阶段的稳定性。货架期内的稳定性非常重要,它决定了我们食用产品时包含的活菌数。益生菌通过消化道时的稳定性,也就是我们通常所说的耐酸、耐胆汁能力,它决定了有多少比例的益生菌能够活着到达起作用的位置。益生菌的稳定性,既跟菌株种类有关,也跟产品的生产工艺有关。
⑤ 看品控: 对于益生菌这类微生物制品而言,生产过程中的污染控制尤为重要。在培养益生菌的时候,如果有其他微生物的污染,这些污染菌可能也会大量扩增。因此,严格的产品质量检测非常重要。当然,对于普通消费者而言,并不容易判断品控,在这种情况下,选择行业知名度高的大品牌益生菌,质量通常是更有保证的。

益生菌产业在我国发展时间较短,且发展极为迅速,法规和监管手段还存在滞后性。© Drdavisinfinitehealth.com
前面提到,目前益生菌市场的法规和监管手段仍有待完善,但我认为整体形势还是向好的。2022 年,中国食品科学技术学会发布的《食品用益生菌通则》团体标准已经正式实施,它对食品用益生菌的基本要求、菌株水平、生产过程、技术要求、贮存和运输、在食品中的应用及标签标识等内容都进行了规范。随着益生菌行业的持续发展,国内各大益生菌相关企业也都在积极地发起和参与益生菌相关标准的制定。
而在此之前,我们不妨去选择有良好售后保障的品牌,在食用之后多细心观察,如果感觉收效甚微,完全可以向产品的售后咨询,及时调整用法,或更换其它更合适的益生菌菌株。
